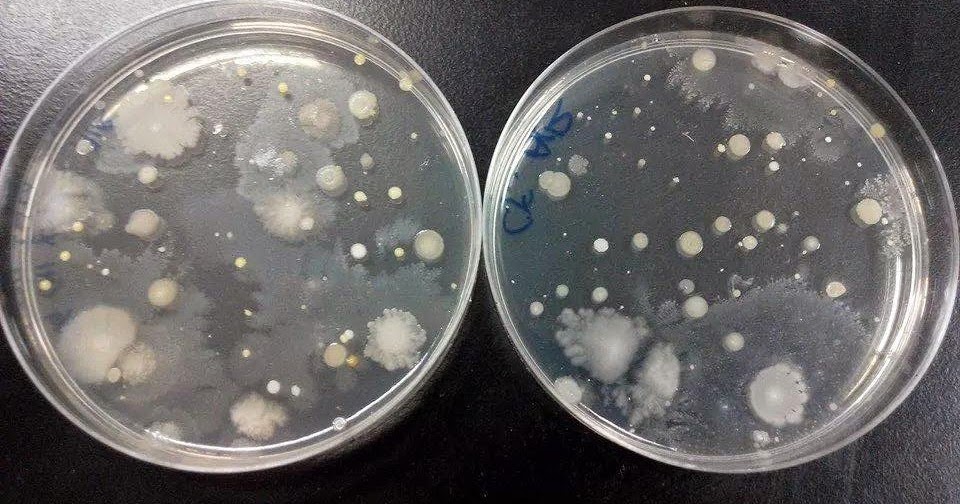
IBG 102 LAB REPORT: LAB REPORT 4 : Sources of Contamination and Infection

circulatory system respiratory system
Fancy Goose Breeds - Poultry Hub Australia we have 13 Images about Fancy Goose Breeds - Poultry Hub Australia like Pixilart - The respiratory and circulatory system working together by, Circulatory/Respiratory System and also ANAT2511 Respiratory System - Embryology. Here you go:
Fancy Goose Breeds - Poultry Hub Australia
 www.poultryhub.org
www.poultryhub.org
gander toulouse
Respiratory System Stock Footage Video | Shutterstock
) www.shutterstock.com
www.shutterstock.com
system circulatory body loop respiratory human transition footage shutterstock systems
Internal Anatomy - Digestive System - Chicken Anatomy
 chickenanatomy.weebly.com
chickenanatomy.weebly.com
digestive cavity
IBG 102 LAB REPORT: LAB REPORT 4 : Sources Of Contamination And Infection
labreport102.blogspot.com
labreport102.blogspot.com
contamination lab report
Cat Dissection- Circulatory System - YouTube
 www.youtube.com
www.youtube.com
dissection cat system circulatory
Kennedy Clan Science: April 2016
 kennedyclanscience.blogspot.com
kennedyclanscience.blogspot.com
system circulatory together respiratory april does
ANAT2511 Respiratory System - Embryology
 embryology.med.unsw.edu.au
embryology.med.unsw.edu.au
pharynx embryology respiratory system file unsw med edu
Circulatory/Respiratory System
 margotlamie.weebly.com
margotlamie.weebly.com
system respiratory
Pixilart - The Respiratory And Circulatory System Working Together By
 www.pixilart.com
www.pixilart.com
circulatory system respiratory together working pixilart
Male & Female Reproductive System Anatomical Charts – Anatomy Posters
 anatomyposters.com
anatomyposters.com
anatomical
AS PE Effects Of Long-Term Exercise On The Respiratory System - YouTube
 www.youtube.com
www.youtube.com
exercise respiratory effects term system
Breathing | Circulatory And Respiratory Systems | Siyavula
 itsi.intelligentpractice.co.za
itsi.intelligentpractice.co.za
respiratory circulatory grade systems system lungs natural siyavula science sciences breathing components gr9 za read
10 Effects Of Smoking Cigarettes
 www.medicalnewstoday.com
www.medicalnewstoday.com
smoking cigarettes
Digestive cavity. As pe effects of long-term exercise on the respiratory system. Kennedy clan science: april 2016